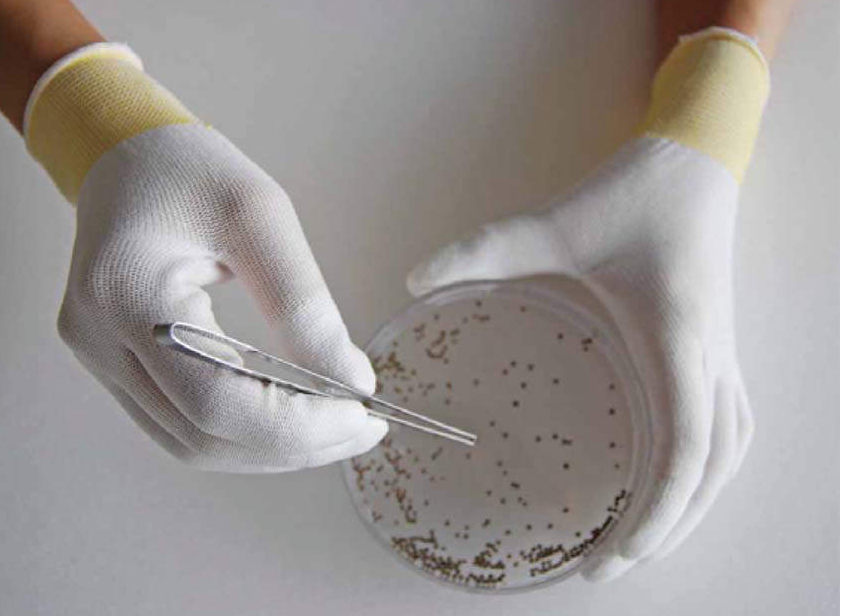

防尘手套
-
- 防尘手套
- SANSYO三商
- B0601
- 日本
- 现货
产品详细介绍
低発塵性手袋 DUST RESISTANT GLOVES
- ホコリが発生しにくい長繊維を採用し、手袋からの異物混入リスクを軽減します。
- 指先に発泡ポリウレタンを立体コート。
- 高い滑り止め効果を発揮し、通気性にも優れています。
- 指サック特有のムレ・圧迫感から解放されます。
- 左右兼用。
| 商品CD |
21-0353 |
| カタログ商品名 |
トップフィット手袋 |
| 型式 |
B0601 |
| |
|
| サイズ |
S |
| 材質 |
繊維部:ナイロン、ポリエステル 樹脂部:ポリウレタン |
| 入数 |
1双×10袋 |